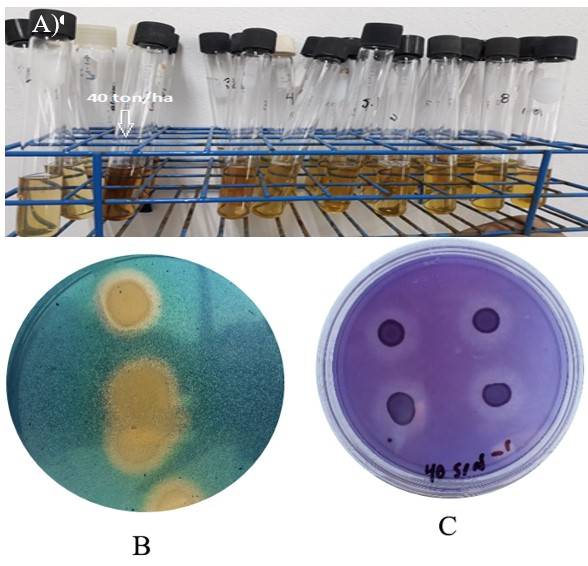

Introducción
El tomate (Solanum lycopersicum) es una hortaliza muy cultivada y consumida, con producción global de 243 635 433 t en 2019. El principal productor fue China, con 125 739 004 t y México ocupó el décimo lugar, con una producción de 3 441 639 t (FAOSTAT, 2021). En 2019, el estado de Coahuila, México, produjo 121 579 t, con un valor de MXN 816 millones. En la Comarca Lagunera, hay 1090 ha de invernaderos y casas de sombra para producción de tomate, generando una cosecha de 145 769 t, con un rendimiento de 135 t ha-1 y una producción valor de MXN 911 369 000 (SIAP, 2021).
La alta productividad del cultivo depende del uso de altas cantidades de fertilizantes químicos, lo que ha agravado una serie de problemas, entre ellos la salinización de los suelos en la región. Por ello, se debe promover el uso de alternativas como la biofertilización y los abonos orgánicos. El uso de biofertilizantes para incrementar la producción de los cultivos se ha intensificado en la última década, tomando en cuenta sus ventajas para el suministro de nutrientes, el estímulo del crecimiento de las plantas y la protección contra agentes patógenos (Ahmed et al., 2021).
Los microorganismos benéficos representan una opción que fortalece el enfoque de la agricultura sustentable (Pretty et al., 2008; Bhattacharyya y Jha, 2012), debido a que incrementan los rendimientos al estimular el crecimiento de las raíces y aumentar la absorción de nutrientes del suelo, contribuyendo así a una mejor nutrición de los cultivos (Raffi et al., 2020). La inoculación con bacterias, entre ellas las del genero Bacillus, ha mejorado el crecimiento y desarrollo del cultivo de tomate y mejoran su calidad nutracéutica (Chandrasekaran et al., 2019).
Por otra parte, la conversión de desechos orgánicos en composta reduce la contaminación ambiental y genera un fertilizante y mejorador de suelos (Chia et al., 2020). El uso de estiércol de bovino solarizado puede aportar materia orgánica y nutrientes al suelo, mejorarar sus características físicas y químicas, y favorecer la población microbiana presente, mientras que reduce algunas enfermedades inducidas por hongos fitopatógenos (López et al., 2014).
Las ventajas en la producción de tomate al emplear estiércol composteado son reconocidas (Ravindrana et al., 2019) y suelen incrementarse cuando el abono orgánico se complementa con la actividad de las rizobacterias (Khan et al., 2021). El presente trabajo se estableció con los objetivos de caracterizar una bacteria aislada de la endorizosfera de plantas de tomate y evaluar su uso sola y en combinación con estiercol solarizado para promover el crecimiento y rendimiento de tomate tipo saladette bajo condiciones de invernadero.
Materiales y métodos
El aislamiento y caracterización de la bacteria se llevó a cabo en el laboratorio de Ecología Microbiana de la Facultad de Ciencias Biológicas, UJED y el estudio en invernadero se llevó a cabo en el ejido Sapioriz municipio de Lerdo, Durango, durante el ciclo agrícola primavera-verano 2021.
Aislamiento de bacterias
Se seleccionaron plantas de tomate con caracateristicas destacables en cuanto a rendimiento y calidad de frutos, que provenían de una malla sombra ubicada a 21 km de la carretera Torreón-San Pedro, Coahuila, México en el paralelo 25° 43’ 30’’ latitud norte 103° 19’ 19’’ longitud oeste. Muestras de la raíz de las plantas seleccionadas se tomaron con una espátula y pinzas estériles, se colocaron en tubos Falcon de 15 ml dentro de un contenedor con hielo se transportaron al laboratorio de Ecología Microbiana de la Facultad de Ciencias Biológicas-UJED.
Para el aislamiento, se pesó un gramo de raíz, se lavó con etanol al 70% y se enjuagó con buffer de fosfatos (PBS) estéril 0.5x. Posteriormente, se maceró con un mortero estéril con 10 ml de solución de PBS 0.5x, se realizaron diluciones seriadas (10-1, 10-2 y 10-3) y se inocularon 100 µl en placas de Petri con medio de cultivo libre de nitrógeno (NFb) con rojo congo y se incubaron a 30 °C durante 1-3 días. Una vez que se observaron las colonias, se procedió a purificar aquellas que se tornaron de un color rojo escarlata. Por último, se preparó una suspensión de bacterias puras en glicerol al 70% y se almacenaron a -70 °C para su conservación.
Identificación de la rizobacteria
Tinción de gran
Cuando la bacteria fue debidamente purificada se realizó tinción de gram para su observación bajo el microscopio compuesto.
Análisis molecular
La identificación de la bacteria, se llevó a cabo por medio de la extracción de DNA utilizando la técnica de CTAB 2x, de acuerdo al método de Doyle y Doyle (1990), luego se realizó la amplificación parcial del gen 16S rRNA por medio de PCR usando los oligonucleótidos 27F 5’AGAGTTTGATCMTGGCTCAG 3’ y 1492R 5’GGTTACCTTGTTACGACTT 3’. El programa de amplificación consistió en 5 min 94 °C, 35 ciclos de 45 s 94 °C, 1 min 50 °C, 1 min 72 °C y finalmente 5 min 72 °C. El producto de la PCR se envió a secuenciar a McLAB en San Francisco, CA, EE UU. Las secuencias obtenidas se analizaron mediante el programa BioEdit 7 y se sometieron a comparación usando Blast (NCBI) (http://blast.ncbi.nlm.nih.gov/Blast.cgi) para determinar su identidad taxonómica.
Caracterización de la rizobacteria
La capacidad de la bacteria para producir ácido indol acético (AIA) se dterminó en medio NFb adicionado con L-triptófano, mediante la técnica de Salkowsky modificada y descrita por Bric et al. (1991). La concentración de AIA fue cuantificada colorimétricamente a 620 nm y comparada con una curva estándar (0.5, 5, 25, 50, 75 y 100 µg ml-1). La producción de sideróforos se determinó utilizando el medio Chrome azurol S (CAS), (Sigma-Aldrich) (Schwyn y Neilands, 1987). La presencia de sideróforos fue confirmada por la formación de un halo claro en torno a la colonia bacteriana.
La solubilización de fosfatos se determinó con el medio de cultivo National Botanical Research Institute Phosphate growth médium (NBRIP) (Nautiyal, 1999). La medición de los halos de solubilización se realizó con un vernier digital (Carbon Fiber Composites Digital Caliper, Industrial & Scientific) y se calculó el índice de solubilización (IS) e índice de producción (IP) con ayuda de la fórmula IS o IP (según corresponda). Cada una de las pruebas se realizó por triplicado.
Preparación del inóculo para experimento en invernadero
La bacteria se reactivó un medio de cultivo NFb con rojo congo y ácido málico como fuente de carbono. Las condiciones de incubación fue agitación continua a 120 rpm y una temperatura de 30 °C. Entre 14 y 16 h (fase logarítmica), se determinó la concentración bacteriana en un espectrofotómetro (Espectro Maestro Fisher Scientific 415) midiendo la absorbancia a 540 nm. La suspensión se ajustó a una absorvancia 1, equivalente a 1 ×106 UFC ml-1 y se preparó una concentración 1 ×108 UFC ml-1 para establecer los tratamientos que se muestran en el Cuadro 1.
Cuadro 1 Tratamientos establecidos con la rizobacteria y dosis de estiércol solarizado en plantas de tomate en condiciones de malla sobra.
| Tratamientos | Descripción |
| T1= (Bc) | Solo bacteriaz |
| T2= control | Control sin bacteria, sin estiércol |
| T3= (Bc) + M40 | Bacteria + estiércol solarizado (40 t ha-1) |
| T4= M40 | Estiércol Solarizado (40 t ha-1) |
| T5= (Bc) + M80 | Bacteria + estiércol solarizado (80 t ha-1) |
| T6= M80 | Estiércol solarizado (80 t ha-1) |
| T7= (Bc) + FQ | Bacteria + fertilización química |
| T8= FQ | Fertilización química |
Z= la rizobacteria se inoculó a una concentración 108 UFC ml-1 en los tratamientos correspondientes.
Solarización del estiércol
El estiércol proviene de un establo 12 días después de ser evacuado por ganado lechero raza Holstein, alimentado con fórmula rica en proteínas que se compone de 1.8 kg de maíz partido, 0.9 kg de salvado de trigo, 0.5 kg de soja y 1.3 kg de minerales (sales Mg++ y K+). Se cubrió durante 90 días con plástico transparente (Plastic Poly Sheeting) de 30 micras de espesor sin albedo, con temperaturas de 60 ±3 °C. Al final el estiércol mostró pH de 7.79, CE de 6.8 dS m-1, 5.35% de materia orgánica, nitrógeno total de 0.86% y 0.084 mg kg-1 de NH4. Finalmente, el abono se aplicó al sitio experimental 30 días antes de la siembra y se incorporó a una profundidad de 30 cm.
Fertilización química
Consistió en una fórmula de 366 -95 -635 (N-P2O5-K2O). Los fertilizantes aplicados fueron urea (CO (NH2) 2: 46% -00% -00%), fosfato monoamónico (11% -52% -00%) y NK (12% -00% -46%). El nitrógeno se dividió en tres partes iguales (cinco días antes del trasplante, floración y fructificación) y se aplicó a un lado de las plantas. El fertilizante a base de fósforo se administró cinco días antes del trasplante.
Inoculación de semillas de tomate
Semilla de la variedad Top 2299 (Ahern Seeds®), tipo saladette se lavó con agua destilada estéril para eliminar productos químicos. Después, se sumergieron en alcohol al 70% durante 10 s, se lavaron con agua destilada estéril. Se sumergieron en hipoclorito de sodio al 2% por 2 min y después en agua destilada estéril. Las semillas se inocularon al sumergir un gramo (360 semillas g-1 ±5) en una suspensión bacteriana 1 × 108 UFC ml-1 durante 1 min. Posteriormente, la semilla inoculada se colocó en un matraz Kitazato de 50 ml y se sometió individualmente a un vacío a 600 mm Hg por 5 min.
Luego, las semillas se colocaron en contenedores de crecimiento que contenían un sustrato pit most previamente desinfestado. Se cubrieron con un hule negro durante 24 h. Una vez que se inició la emergencia, los contenedores se colocaron en condiciones de invernadero (36 °C, HR 40% y 3 000 lux) durante 45 días. Las plántulas se inocularon a los 14 y 26 días después de la siembra, sumergiendo el sistema radicular en una solución de base bacteriana 1 × 108 UFC ml-1.
Establecimiento en invernadero
Se seleccionaron plántulas por su buena apariencia y se trasplantaron a un suelo en melgas de 10 m de largo y un metro de ancho, con un lineal de cinco plantas por metro en lechos de un metro de ancho y una distancia entre lechos de 1.4 m. En cada lecho había 50 cm entre filas de cada tratamiento. Las características del suelo fueron: textura franco arenosa, con un pH de 6.5, CE de 1.6 dS m-1, 1.4% de materia orgánica, 10.25 mg kg -1 de nitrógeno total, 10.2 ppm de NO3 y 15.16 mg kg-1 de NH4. El ambiente dentro del invernadero se muestra en el Cuadro 2.
Cuadro 2 Condiciones ambientales (temperatura, humedad relativa, insolación media anual y radiación fotosintéticamente activa) durante las diferentes etapas fenológicas de la producción de tomate saladette (variedad TOP 2299) tratado con bacterias y estiércol.
| Etapa fenológica | T (°C) | HR (%) | RFA(meq m-2 s-1) | IMA (h día-1) |
| Plántula/trasplante (abril) | 39 ±2 | < 39% | 540.33 | 13.2 |
| Prefloración (mayo) | 39 ±3 | < 42% | 535.22 | 13.3 |
| Floración y fructificación (junio-julio) | 37 ±3 | < 50% | 520.32 | 11.5 |
| Cosecha (agosto) | 35 ±4 | < 46% | 478.43 | 10.4 |
T= temperatura; HR= humedad relativa; RFA= radiación fotosintéticamente activa; IMA= insolación media anual. Datos del invernadero.
Manejo del cultivo
Se efectuó una poda a las plantas a los 60 días y guiadas a dos tallos. El control de plagas de insectos incluyó Beauveria bassiana, extractos de ajo y orégano. El riego se suministró, según la etapa fenológica del cultivo, mediante un sistema por goteo superficial monitoreado con tensiómetros modelo SR 24”, el Irrometer®. El agua se caracterizó por pH de 5.2, CE de 2.5 dS m-1 y 0.23 ppm de NO3. La cosecha inició cuando el 30 a 60% de la superficie de los frutos mostró un color rosado, según la clasificación de color (Coromoto et al., 2018).
Diseño experimental y análisis estadístico
El estudio consistió en ocho tratamientos que fueron analizados en un diseño experimental bloques al azar con arreglo factorial. Las variables de respuesta fueron altura de planta, volumen de raíz y rendimento. Se realizó un Anova seguido de una prueba de Tukey (p= 0.05). Los análisis se realizaron utilizando el programa SAS.
Resultados y discusión
Identificación de la rizobacteria
La rizobacteria se caracterizó por su forma de bacilos cortos y de color rosa, lo que indicó que es gram positiva (Figura 1). El análisis de la secuencia del gen 16S rRNA mostró alta homología con secuencias de Bacillus cereus reportadas en el GenBank del NCBI (Cuadro 3).

Figura. 1 Características de la bacteria observadas durante la tinción de gram mostrando bacilos cortos y de color rosa (gram positiva).
Cuadro 3 Identificación molecular de las rizobacteria aislada de plantas de tomate.
| Género/especie | Tamaño de secuencia (bp) | Identidad(%) | Núm. de acceso |
| Bacillus cereus | 963 | 99.76 | EU327888.1 |
Las bacterias pueden ser importantes aliados de las plantas, ya que algunas cuando se encuentran en interacción producen diversos metabolitos que estimulan o inhiben rutas metabólicas que favorecen el crecimiento vegetal (Glick, 2012). En el caso particular del cultivo de tomate, las plantas se benefician de su interacción con estas bacterias (Noh et al., 2014). Coincidentemente, en este trabajo la cepa nativa de B. cereus se encontró en plantas de tomate con características de alto rendimiento y buena calidad de frutos.
En la interacción tomate-B. cereus la presencia de la bacteria favorece el crecimiento del cultivo aún en condiciones de estrés (Khan et al., 2020; Mukhtar et al., 2020) y mejora su sanidad por el antagonismo contra hongos de importancia como Fusarium oxysporum y Alternaria solani (Karthika et al., 2020) o al modificar los exudados radicales de las plantas para inducir control de Ralstonia solanacearum (Wang et al., 2019).
Caracterización de la rizobacteria
La bacteria mostró capacidad para producir AIA (5.9 µg ml-1) (Figura 2A) y sideróforos, expuestos por la formación de un halo color cristalino alrededor del crecimiento bacteriano, el cual alcanzó 6.54 mm (Figura 2B). La solubilización de fosfatos fue detectada por la formación de un halo de 5.12 ±0.702 mm en torno a la bacteria (Figura 2C).
Figura 2 Capacidad de B. cereus para producción de: A) AIA en medio NFb complementado con L-triptófano; B) producción de sideróforos en medio CAS; y C) solubilización de fosfatos en medio NEBRIP.
Los mecanismos para la promoción del crecimiento vegetal por bacterias pueden ser diversos y complejos (Glick, 2012). En el caso de la cepa nativa de B. cereus, puede ser que los efectos benéficos son consecuencia de la producción de reguladores de crecimiento y de la absorción de macro y micronutrientes (Beltran et al., 2020).
La producción de AIA se relaciona con el desarrollo de la raíz, la proliferación de raíces laterales y de pelos radiculares, que mejoran la absorción de agua y nutrientes (Spaepen et al., 2014). La producción de AIA por rizobacterias es bien conocida, además de que estimulan a las plantas para que incrementen la producción endógena de esta auxina (Haque et al., 2020). Los sideróforos mejoran la asimilación de minerales como fierro, zinc y cobre y promueven incrementos en la longitud de tallos y raíces y en la acumulación de biomasa (Karthika et al 2020; Zhao et al. 2020).
La producción de AIA y sideróforos promovieron cambios importantes en la arquitectura de raíz y tallos de las plantas de tomate, que se complementaron con la solubilización de fosfatos, Haque et al. (2020) necesarios para la regulación de varios procesos como la síntesis de proteínas, la actividad enzimática, la fotosíntesis y la tolerancia al estrés abiótico (Tariq et al., 2017).
Crecimiento de invernadero
Se observaron diferencias significativas entre los factores estudiados. El crecimiento de las plantas fue mejor en la combinación B. cereus + 40 t ha-1 de estiércol solarizado, que igualaron o superaron el crecimiento de las plantas fertilizadas químicamente (Cuadro 4). La variable más favorecida fue volumen de raíz (42%), seguida del rendimiento (20%) y altura de la planta (16%). Para las tres variables existió interacción entre factores bacteria y estiércol solarizado (Figura 3).
Cuadro 4 Efecto de B. cereus y estiércol solarizado e interacción, sobre las variables altura de planta, volumen de raíz y rendimiento de plantas de tomate.
| Factor | Altura de planta (m) | Volumen de raíz (ml) | Rendimiento (kg m-2) |
| Estiercol solarizado | |||
| 0 | 2.35 ±0.09 b | 56.66 ±12.5 c | 9.83 ±0.77 b |
| 40 | 3.17 ±0.35 a | 97.5 ±40 a | 12.2 ±1.99 a |
| 80 | 2.68 ±0.67 b | 71.33 ±23 b | 10.56 ±1.2 b |
| Fertilización química | 3.16 ±0.7 a | 83.83 ±15 b | 12.45 ±1.45 a |
| Inoculación | |||
| B. cereus | 3.21 ±0.5 a | 76.61 ±38.5 a | 12.31 ±1.6 a |
| Sin B. cereus | 2.74 ±0.53 b | 54.33 ±24.5 b | 10.07 ±1.9 b |
| Bc+ estiercol solarizado | |||
| * | * | * | |
Medias de los tratamientos ± desviación estándar. Para cada variable, valores para cada factor con letras desiguales son estadísticamente diferentes (Tukey p≤ 0.05); *= indica interacción estadísticamente significativa entre bacteria y estiércol solarizado (Tukey p≤ 0.05).

Figura 3 Interacción de B. cereus-fertilización en altura de la planta (a); volumen de raíz (b); y rendimiento por m 2 (c). Valores 0, 40, 80= t ha -1 de estiércol. FQ= fertilización química. Las diferentes literales indican una diferencia significativa (Tukey (p≤ 0.05).
Estos resultados demuestran que el crecimiento de las plantas de tomate fue favorecido con la inoculación de B. cereus sola y en combinación con estiércol solarizado. La altura de las plantas inoculadas fue mayor al de plantas no inoculadas, al igual que el volumen de raíz lo cual mejora su capacidad de exploración y las posibilita para asimilar mayor cantidad de nutrientes presentes en el suelo (Khoshru et al., 2020). Estas mejoras en el crecimiento propiciaron incrementos importantes en la producción de frutos.
El estiércol ayuda a mantener la disponibilidad de nutrientes y el estatus nutricional de las plantas, mejora las condiciones físicas y químicas del suelo e incrementa el contenido de materia orgánica, que además provee carbón orgánico que favorece las actividades microbianas (Khan et al., 2021). Estos beneficios se complementan con la capacidad de la cepa nativa de B. cereus para producir de AIA, sideróforos y solubilizar fosfatos.
Adicionalmente, la combinación bacteria-abono orgánico causa una reducción de la salinización que es detrimental para el crecimiento del cultivo, de tal forma que al reducirla se generan condiciones que interactúan positivamente con la producción de frutos (Zhang et al., 2019).
Estos autores refieren también que el uso combinado de B. cereus con abono orgánico suele mejorar la eficiencia de uso del nitrógeno. Asimismo, en el suelo el estiércol sufre un proceso de descomposición mineral en el que participa B. cereus y otros microorganismos, rompiendo sus estructuras bioquímicas en compuestos nitrogenados más simples de los cuales las plantas toman nitrógeno en forma de NH4 y NO3 (Andrade et al., 2020).
Estos compuestos se trasladan al tejido vegetal para ser asimilados y sintetizar diferentes compuestos y moléculas, como las proteínas que son indispensables para el correcto funcionamiento celular (Kour et al., 2020). En adición, tanto plantas como microorganismos tienen la capacidad de producir enzimas fosfatasas que suelen combinarse para adquirir el P desde las formas orgánicas de fosfato presentes en el estiércol (Mpanga et al., 2018).
En La Laguna, México, la salinidad y la temperatura suelen alcanzar altos niveles, a los cuales el tomate es muy susceptible (Khan et al., 2020). Consecuentemente, surge la búsqueda de estrategias fisioquímicas y biológicas, amigables con el ambiente que ayuden al cultivo a crecer bajo dichas condiciones. En este sentido, microorganismos como B. cereus ejercen diversos efectos benéficos sobre las plantas, al promover el crecimiento y mitigar los efectos adversos del ambiente (Khan et al., 2020; Mukhtar et al., 2020). Estos benéficios pueden ser mayores cuando estas bacterias se combinan con abonos orgánicos (Pishchik et al., 2018; Khan et al., 2020).
Conclusiones
Los resultados de este estudio demuestran que la cepa nativa de B. cereus desarrolla mecanismos como la producción de ácido indol acético y sideróforos, así como la solubilización de fosfatos, que le confieren la capacidad de promover el crecimiento de las plantas de tomate al mejorar su desarrollo aéreo y radicular que llevan a importantes incrementos en la producción de frutos.
La combinación de esta bacteria con estiércol solarizado igualó el crecimiento y los rendimientos de plantas fertilizadas químicamente, por lo que es factible considerar esta combinación para elaborar un biofertilizante para el cultivo de tomate.










texto en 


